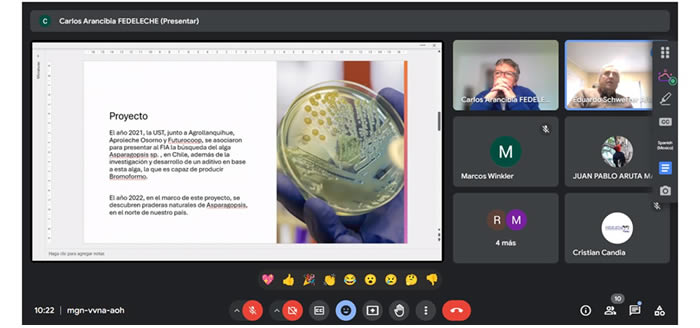

Directorio de Fedeleche discute la marca sectorial, regulaciones de emisiones y proyecto de investigación sobre metano.
En un escenario sectorial con múltiples desafíos y una creciente preocupación por la sostenibilidad, la Federación Nacional de Productores de Leche (Fedeleche) analizó las líneas de trabajo en temas relacionados con la marca sectorial, impacto de regulaciones y proyecto de investigación sobre metano.
La reunión mensual de directorio celebrada de manera remota este martes 23 de julio de 2024 contó con los representantes gremiales de las asociaciones adheridas a la Federación Nacional: Aproleche Ñuble, Aproleche BioBio, Aproleche Araucanía, Saval, Aproleche Osorno y Agrollanquihue.
El presidente de Fedeleche, Marcos Winkler, destacó la importancia de la colaboración entre las asociaciones gremiales y la necesidad de abordar de forma coordinada y activa los diferentes temas regulatorios y los desafíos que el sector lechero debe encarar y resolver.
De esta manera, y tras analizar los últimos antecedentes, el directorio de Fedeleche ve necesario resolver la interpretación de normas ambientales concernientes al sector y acordó activar gestiones con el Ministerio de Agricultura para transmitir estas inquietudes a la autoridad.
Los personeros del gremio revisaron la normativa de emisiones del Ministerio de Medio Ambiente para tractores, Norma Tier 4 y Euro 6, que comenzará a regir en octubre de este año, advirtiendo un impacto negativo en la agricultura. La alerta ya ha sido encendida ante los parlamentarios para establecer medidas que permitan derogar y revertir la entrada en vigencia de esta norma.
Desde el gremio se advierte preocupación, ya que no solo afectará la compra de maquinaria, sino que además en competitividad, lo que se suma a otros problemas como el alza tarifaria del sistema eléctrico que se teme afectará considerablemente tanto en la producción de leche, como en el riego mecanizado.
Asimismo, se aproxima la implementación de la nueva ley de delitos económicos y ambientales, normativa que demanda difusión de información hacia los agricultores para que puedan comprender y aplicar las medidas necesarias y cumplir con esta regulación.

El presidente de Fedeleche, Marcos Winkler, destacó la importancia de la colaboración entre las asociaciones gremiales.
En otros ámbitos del quehacer gremial, el gerente de Fedeleche informó sobre la Ley de etiquetado, sin reglamento a cinco años de su promulgación, mientras el presidente informó sobre los avances de la marca sectorial Chilemilk, mencionando reuniones con la industria y el apoyo de ProChile y Odepa. Marcos Winkler destacó que la marca sectorial potenciará el posicionamiento en el comercio internacional, especialmente en mercados como México y China.
De igual modo, el directorio de Fedeleche conoció los resultados preliminares del 10° Congreso Chilelácteo 2024, punto de encuentro de la cadena láctea nacional, organizado en Osorno por el gremio el 26 y 27 de junio pasado. En general, se destacó el ánimo y los comentarios positivos recibidos sobre la organización y las charlas, y la necesidad de buscar formas de hacer expandir el evento en el futuro. Se informó sobre 600 inscritos entre productores, autoridades, representantes de la industria, empresas proveedoras y académicos vinculados al sector lácteo.
Directorio de Fedeleche conoció avances del proyecto de investigación para reducir la producción de metano mediante el uso de algas.
Directorio de Fedeleche conoció avances del proyecto de investigación para reducir la producción de metano mediante el uso de algas.
Investigación sector lácteo
Mediáticamente se habla bastante de la emisión del metano por parte de los rumiantes, pero menos de la contribución que hace el sector para mitigar sus efectos. Eduardo Schwerter, director por Agrollanquihue presentó a las asociaciones gremiales el proyecto de investigación en colaboración con la Universidad Santo Tomás para reducir la producción de metano en rumiantes mediante el uso de algas.
Tras relevar la importancia que tiene la investigación como en base en el sector lácteo, el directorio de Fedeleche acordó revisar más detalles y discutir en una próxima reunión presencial la propuesta de investigación, la viabilidad y las implicaciones de financiar el proyecto y coordinar acciones futuras.
En otras materias, el gerente de Fedeleche informó sobre el trabajo en la segunda versión de la publicación de Indicadores Sectoriales 2023 y sobre una visita a un campo en Peñaflor con la sectorialista de Odepa. Además, del proyecto de ley que regula la industria Food que establece un estatuto de libre competencia entre alimentos de origen animal y vegetal.
Finalmente, el estamento gremial destacó la importancia de la participación activa de los gremios para seguir avanzando en temas claves y acordó realizar la próxima reunión en Santiago de manera presencial para discutir temas importantes en mayor detalle.
Fuente: Comunicaciones Fedeleche FG



